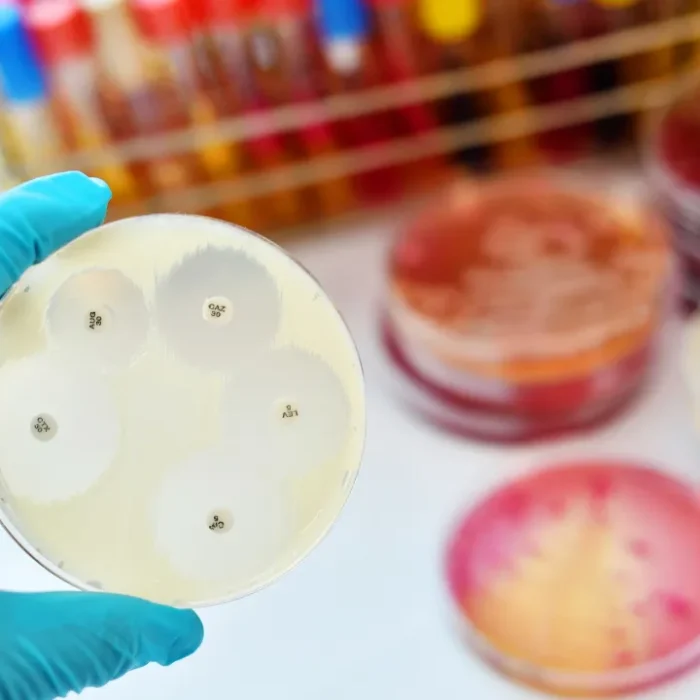
World Health Expo - Travflix Tours

CPHI Milan 2026
Explore CPHI Milan 2026, Europe’s leading pharmaceutical exhibition in Italy. It brings together global pharma leaders showcasing APIs, excipients, finished formulations, contract manufacturing, and packaging innovations.
- 6 – 8 October, 2026
- Fiera Milano, Milan, Italy

pharmaceutical
A Defining Era for Global Pharmaceutical Innovation in Milan.
CPHI Milan 2026 is Europe’s leading pharmaceutical exhibition, bringing together the entire global pharma value chain under one roof. Hosted in Milan, the event serves as a premier international platform for pharmaceutical ingredients, APIs, biotech solutions, contract development and manufacturing (CDMO), advanced packaging technologies, and industry services.
Visitor Industries
At CPHI Milan, visitors typically come from a variety of industries and roles such as:
- Pharmaceutical Manufacturers
- API & Intermediate Manufacturers
- Chemical & Specialty Ingredient Companies
- Quality Control, Testing & Regulatory Services
- Distributors, Traders & Supply Chain Companies
- Healthcare, Medical & Life Sciences Companies
Why Choose Us?
- Decades of trusted industry expertise
- Personalized service tailored to your business needs
- Reliable, efficient, and professional support
- A commitment to making your trade fair experience exceptional
Dear Valued Client
We are excited to introduce Travflix Tours, your dedicated partner in trade fair travel solutions. Built on decades of mastery in logistics and event management, we transform the complexities of trade fair travel into effortless, tailor-made experiences.
At Travflix Tours, our philosophy is simple: Travel Made Personal. Whether you’re traveling alone or with a team, we provide comprehensive support—from logistics and accommodation to on-ground assistance—so you can focus on what matters most: your business.
We look forward to helping you make your next trade fair experience successful and stress-free. Please do not hesitate to reach out for customized travel solutions or any assistance you may require.
- Package Details
- Package Itinerary
- Visa Information
- Booking Confirmation
Package Inclusions
- Accommodation on Twin Sharing or Single Occupancy
- Daily Buffet breakfast
- Return Airport – Hotel – Airport transfers (as per group flight)
- Fairground transfers as per itinerary
- Indian Dinners in the comfort of hotel + 1 Networking night
- Milan City tour with Duomo shopping drop
- Daily 2 (500 ml) water bottles per person
- Schengen Visa
- Overseas Travelers Mediclaim Policy till age 60 years
- Services of an Experienced Travflix Tour Leader
Package Exclusions
- Airfare
- Entrances to the fairground
- Lunches
- Laundry Porterage, excess baggage & expenses of personal nature
- All Items Specified in ‘Extras’& any other items not mentioned in Inclusions.
Mandatory Extras
- GST – 5% chargeable on total package price
- TCS – 20% chargeable on Foreign Currency Component of the package
- TCS is not applicable if 2% TDS is deducted under SECTION 194/C
- Tips to Coach Driver & Guide – USD 25 per person
- Increase in foreign exchange rate will be charged extra
Upon Booking Confirmation
- Filled in Registration Form (Mandatory) - https://forms.gle/WsHVnomb6rbVPnd18
- Payments to be made by Cheque or Bank Transfer (RTGS / NEFT)
- Cheque in favor of – Travflix Tours Private Limited
- Bank Name: HDFC Bank
- A/C No.: 50200106139380
- IFSC: HDFC0000424
- Branch Name: Matunga East
- PAN Number – AALCT6677N
- Udyam Registration Number – Udyam -MH – 19-0366130
- GST Number - 27AALCT6677N1ZA
- Arrive in Milan
- Check-in at hotel
- Visit CPHIww Milan ’26
- Visit CPHIww Milan ’26
- Visit CPHIww Milan ’26
- Milan City Tour with Shopping drop in Duomo
- Check-out & depart
Visa Information
- (APPLIED THROUGH VFS) KINDLY PROVIDE ALL THE DOCUMENTS IN A4 SIZE. PLEASE DO NOT STAPLE ANY DOCUMENTS
- Original Passport (Old and New) valid for 6 months and require
- Online visa form duly filled with barcode with three signatures on visa
- form [For online form, please visit https://videx.diplo.de/ along with 2 copies of declaration form and courier form – Sample visa application form is attached
- Two Recent Photographs white background without border, 35mm x 45mm, 80% of the face should be seen (Should be without glasses with glasses photo will not be accepted) (Photographs should not be old for more than 6 months)
- Covering letter addressed to ` consulate General of Germany, Mumbai` along with passport details, travel dates, and purpose of travel in Company letterhead with seal and address and contact number.
- Invite letter in Company letterhead with seal and address and contact number, details like travel dates in and out, passport number, designation, a brief company profile and other details about trip and expenses.
- Copy of the Income Tax Papers for 3 years
- Updated Bank statement for the last 3 months with applicant`s name, a/c no. with bank seal and sign
- Return ticket (ticket should have a gap of at least 15 working days from the date of submission).
- Applicant traveling for the first time have to carry salary slip for 3 months, appointment letter from the current company and educational certificates.
- Company Registration copy.
- ITR 2 years
Tour Specific Terms & Conditions
- This quote is just an offer based on 40-50 Adults travelling together at all times.
- No services have been blocked, unless specifically mentioned above. All services given will be confirmed post a written acceptance of the quote & payment of a deposit & the associated terms and conditions of the tour.
- All services offered are based on the availability at the time of quote. In case, same room-type/hotel/airline/etc. are not available, on best effort basis we will provide you an alternate hotel in the equivalent/similar category. Any impact on prices due to the same will be borne by the customer.
- For Booking this tour package you are requested to give confirmation by e-mail along with MOU/Booking Form/Purchase Order with relevant details mentioned & duly signed. This confirmation will mean an acceptance of all the terms and conditions of this quote.
- For booking, we shall require a copy of the Corporate PAN Card and PAN card copy of each individual travelling on the tour.
- All our Travel arrangements are sold subject to the given Terms & Conditions in this sheet, and the same shall govern the contract between the client and Travflix Tours Private Limited. By agreeing to avail the services under this quote, you agree to all the terms & conditions.
- The above given tour cost is based on a specific rate of exchange, and the pricing will be altered if there is an increase of more than 1% in the given rate of exchange on the date of payment. The exchange rate provided by Travflix Tours Private Limited designated Foreign Exchange partner will be the reference point for the exchange rate.
- Any and all changes by airlines or any other service provider on the quoted/confirmed prices owing to change in tax structure or any other reason, will have to be borne by the customer.
- Any extra services taken by the customer, authorized by the company representative on tour, will have to be paid in full by the customer on return within timelines as stated in the invoice.
- The tour price is based on the given number of passengers traveling together on the said dates, as given in this quote. Any variation in the number of passengers (total or by hub), or change in the given room configuration or dates, will cause an increase in prices and the same will have to be paid by the client as per the new cost details, which will be provided post intimation of the change.
- The current prices are based on the current taxation in your hub and destination. Any change in the regulation of taxes on your dates of travel will be borne by the customer.
- Travflix Tours reserves the right to change the tour prices for any reasons beyond its control.
- Travflix Tours reserves the right to alter the days and times of operations of above-mentioned services basis local conditions on ground which may force an alteration. Any non-operated services will be refunded subject to refunds form the service providers.
Payments & Cancellations
- If the Client wants to cancel the tour as per timelines given below, he must intimate the Company in writing, mailed to us at our office address on working days within office time, on the contact details shared above.
- If the Booking Form/Purchase Order/Work Order has been signed by one or more persons for themselves and for others mentioned in the form, communication signed by such signatories would be treated as valid communication for cancellation for all such persons mentioned in the form.
- The computation of the period of notice of cancellation shall commence only from the time the written request reached the Company at its dealing on working days within office time. In case of cancellation, the following cancellation charges would apply.
- All services such Hotel accommodation / ground transportation / venues for tours / conferences / events are pre-blocked well in advance.
- We are liable to pay penalties to all our suppliers / vendors if these services are released within the below mentioned time frame.
| PAYMENT TERMS & CONDITIONS | |
|---|---|
| Registration Amount | INR 1,00,000/- |
| To Proceed for Final ticket issuance, Visa processing, Hotel confirmation | 75% of Balance Package Cost |
| Full & Final Payment at time of Handover | 100% Payment |
| CANCELLATION POLICY - AMOUNT TO BE CHARGED | |
|---|---|
| INR 75,000 | Non-Refundable |
| 60% of the package price | if cancelled 60 Days prior to departure |
| 75% of the package price | if cancelled 59-30 Days before departure |
| Full package price | if cancelled within 29 Days before departure |
Refunds
- There is no refund for any unutilized services for any reason whatsoever, and/or if the tour or any part thereof cannot be conducted due to Force Majeure or Vis Majeure. Travflix Tours shall not be liable to give any refund to the Client.
- Refunds (if any) would be paid by the Travflix Tours will be paid to the client in the name of the Corporate Entity.
- It would take at least 45 days to process the refund (if due). In case of refund of foreign currency component, the said refund shall be made in Indian Rupees only at the prevailing buying rate on the date of refund as per existing Rules and regulations.
- All refunds will be subject to a management fee of 5% on the total refund amount.
Scope of Activity
- Travflix Tours is engaged in the business of travel organizer and does not control or operate any airline, neither do own or control any shipping company, coach or coach company, hotel, transport, restaurant, kitchen caravan or any other facility or service mentioned in this quote/Brochure.
- Travflix Tours shall not be held liable or responsible in any manner whatsoever for any reasons including any delay, improper services provided by any agency, airline, transport, hotel, any provider of services, for any injury, death, loss or damage which is caused by the act or default of the management or employees of any hotel, airlines, shipping companies, coach owners /coach operators /tour operators who are the Travflix Tours independent contractors etc.
- Travflix Tours shall not be held liable or responsible for reasons like delay or deficiency in services provided by agency, airline, transport, hotel, any provider of services, and/or any act or actions of co-travelers, co-passengers which may result in injury, damage to the life/limb or property of the Client or interfere with enjoying or availing the services to be provided on the tour etc.
Tour Manager / Guide
- Tour manager/ Guide accompanying the tour will be provided if provided under ‘inclusions’ in this quote.
- Clients must abide by the instructions of the Tour Manager.
- Travflix Tours shall not be liable for any loss or delay etc. caused to the Client due to non-abiding of the Tour Manager instructions by the Client.
Health & Insurance
- It shall be the duty of the Client to inform Travflix Tours in writing (emails permitted) in case the Client has any medical history that may affect his ability to enjoy and pursue fully the tour and wherein the interest of the group or any member thereof is prejudicially affected.
- Travflix Tours reserves the right to ask the Client to provide written certification of his medical fitness before departure. In the event that a medical condition has not been disclosed, Travflix Tours shall not be liable to provide any assistance or refund the money.
- The tour cost does not include the costs towards the insurance premium, unless specifically mentioned in the “Tour Inclusions “section. Hence, it is advisable that the Clients get insurance cover at their own costs.
Conditions of Travel
- The Client will have to strictly follow the Tour Program. There shall be no refund, if the Client fails to join the group at the commencement of the tour or joins the group later or leaves the group before culmination of the tour. It shall be noted that for all purposes, it shall be the responsibility of the Client to reach the place of commencement of the Tour and register with the representative of Travflix Tours at the appointed place, date and time.
- In case where a Client along with his family is compelled to discontinue the tour due to any reason whatsoever including illness, death or loss of any travel documents, no claim shall be entertained for refund of unutilized services. Even if a Client is unable to reach the place of commencement of the tour due to any reason whatsoever including loss of baggage or loss of travel documents, his booking shall be treated as “no show” on the tour and 100% cancellation charges will be levied.
- If a Client avails pre – tour services or part thereof, or the air tickets (if booked under the offer) but fails to join the group for the main tour at the appointed place, or cancels the tour after using the air tickets or pre – tour arrangements or part thereof, it shall be treated as “no show” and there will be no refund whatsoever for the unutilized pre- tour or main tour services.
- Travflix Tours reserves the right to withdraw tour membership of any Client whose behavior is deemed likely to affect the smooth operation of the tour or adversely affect the enjoyment or safety of other passengers and Travflix Tours shall be under no liability to any such person.
- The immunities provided under this contract shall be available to Travflix Tours employees, directors, managers, including, Employees and Agents but not to the Independent Contractors selected by Travflix Tours.
- Each of these conditions shall be severable from the other and if any provision be invalid, illegal or unenforceable, the remaining provisions shall nevertheless have full force and effect. No liability on the part of Travflix Tours arising in any way out of the Contract in respect of any tour, holiday, excursion facilities shall exceed the total amount paid or agreed to be paid for the tour holiday, and Travflix Tours shall in no case be liable for any consequential, incidental loss or additional expense whatsoever.
- It is a condition of Booking that the Client takes out a Travel Insurance – Client may procure travel insurance (optional) at their own cost. Travflix Tours will not provide any assistance in obtaining any travel insurance.
- The prices quoted in this brochure have been calculated at the rate prevailing at the time of printing of this brochure. Travflix Tours reserves the right to amend the prices published in this brochure in case of fuel costs, special/high season charge levied by the suppliers, hike in the airline/rail charges before the date of departure and to surcharge accordingly. The Client must pay for all such increases in price in full before the departure.
- If no suit/action is brought against Travflix Tours within 03 (three) days of the last day of the tour, Travflix Tours shall be discharged from all liabilities under/or arising out of this Contract and the Client shall be deemed to have Relinquished/abandoned all his rights under or arising from this Contract. notice unless a specific assurance of the contrary is published.
Others
- Check-in time for the hotel will be the standard time defined by the hotel and flight timings have no bearing on the same. If the flight is arriving early, hotel does not allow check-in earlier than their standard check-in time. Early check in and late checkout are subject to availability and cannot be guaranteed. Usually, International check in time is 1500 hrs and check out time is 1100 hrs.
- In the event of a client booking through Travflix Tours a Tour or Tour Arrangement of any other Tour Operators etc. the “Terms and Conditions” specified by such Tour Operator (including Airlines, Hotels, and/or any other suppliers), including their payment schedule, cancellation, refund etc. Shall be applicable, in addition to above mentioned “Terms and Conditions” while determining the contractual relation between the Client, the Tour Operator and Travflix Tours.
- There is no refund for any unutilized services/meals (due to any reason) and unutilized services/meals cannot be exchanged for any other service.
- Special requests such as rooms adjacent to a colleague, close to the elevators, etc. should be requested for at the time of booking and will be confirmed subject to availability at the hotel.
- Guests will be charged for full length of stay irrespective of early departures or late check-in.
- In case of an amendment on a confirmed hotel booking, the rates are subject to change.
- All advances paid to the vendors i.e. the Airlines, Hotels, transporters, restaurants etc., on account of the Group arrangements as well as any cancellations charges, thereafter, will be borne by the Client.
- Travflix Tours will try to provide on best effort basis any last-minute services (especially with financial implications) only on a written approval by the authorized Client staff members of the concerned Client.
- Client will allow Travflix Tours to amend / cancel the inclusions or the tour in consultation with the authorized Client Group Staff members, in case circumstances make it necessary or in case of circumstances beyond Travflix Tours control.
- Travflix Tours final invoice will be deemed as the final bill for all the components of the tour (Flight, Hotel, Sightseeing, Events, and/or any other services) by the client.
- Travflix Tours will not provide any supporting bills from the fulfilment vendor (Flight, Hotel, Sightseeing, Events, and/or any other services) as per its own contractual obligation with
vendors/suppliers. - All billing will be as per number of rooms used in the respective hotels in single or doubles / twins and as per the other services utilized.
Liability
A. In the event of Travflix Tours exercising its rights to amend or alter any Tour or holiday advertised in their Brochure/ itinerary after such Tour or Holiday has been booked, the Client shall have the right:
- To continue with the Tour or holiday as amended or altered or to accept any alternative Tour or holiday, which Travflix Tours may offer.
- In either of these above cases the Client shall neither be entitled to nor Travflix Tours be liable to the Client for any damage, additional expenses, consequential loss suffered by him or to pay any amount as refund. In the event that Travflix Tours is unable to conduct a particular Tour Travflix Tours shall at its own discretion, refund the amount of the cost of the said Tour to the Client (after deducting the actual expenses incurred by Travflix Tours on Clients’ booking and on other overheads as applicable from case to case) without any interest on the same. The Client will not be entitled to make any grievance thereafter in respect of the same.
B. Travflix Tours shall, in no circumstances whatsoever be liable to the Client or any person traveling with him for:
- Any death, personal injury, sickness, accident, loss, delay, discomfort, increased expenses, consequential loss and/or damage or any kind of theft howsoever caused.
- Any act, omission, default of any independent contractor or other person or by any servant or agent employed by them who may be engaged or concerned in the provision of accommodation, refreshment, carriage facility or service for the Client or for any person traveling with him howsoever caused.
- The temporary or permanent loss of or damage to baggage or personal effects howsoever caused including willful negligence on the part of any person.
- Loss of baggage by the airlines / coach / train.
- Overbooking of seats by the airline.
- Failure on the part of airline to accommodate passengers despite having confirmed tickets or change of route.
- If in the event that the Client is booked on a particular airline and the said flight is over booked/cancelled for whatever reason and the Client is not allowed/able to board the flight, the Client shall not hold Travflix Tours responsible for the same and no claim whatsoever can be made by the Client against Travflix Tours for refund or compensation.
C. Travflix Tours shall not be responsible and / or liable for any damages caused to the Client due to reasons beyond the control of Travflix Tours (Force Majeure / Vis Majeure).
D. While enjoying the services provided by Travflix Tours, if any Client’s acts or omission results in damage or loss to Travflix Tours vendor or service provider which includes but is not limited to (airlines, hotels, transports etc. and vendors’ staff), the Client shall be liable and agrees to indemnify and hold harmless Travflix Tours its directors, officers or such vendor from and against such claims.
E. The immunities provided under this contract to Travflix Tours shall be available to Travflix Tours Managers, including Tour Managers, Employees, Servants and Agents but not to the Independent Contractors selected by Travflix Tours.
F. Please note that this quote/email and terms & conditions mentioned herein overrides any verbal communication with any of our employees or partners, and no one is authorized to change any of the terms & conditions listed above.
G. Any arrangement that you make with anyone which is in violation of the terms & conditions above will be in violation of Travflix Tours terms of service and Travflix Tours will not be liable for any such arrangements made by you.
Disclaimer
- The Client agrees and acknowledges that they consent to participate in the excursion activities (boat rides, ferry rides, snorkelling etc. which is included in the tour) without any obligation from Travflix Tours. Client confirms that he/she/all tour members is/are medically fit to participate in all activities involved in excursion activities & fully accept his/her personal responsibility of his/her safety.
- Travflix Tours shall not be liable for any physical injury or loss of life caused to the Client due to such participation.
- The Client agrees that booking tour package with Travflix Tours, you agree to receive transaction messages.
Law & Jurisdiction
For all complaints, suits, claims or disputes of whatsoever nature relating to any products including Tours by Travflix Tours and third-party products and tours, the courts and tribunals in Mumbai, India alone shall have exclusive jurisdiction.
Upon Booking Confirmation
- Filled in Registration Form (Mandatory) - https://forms.gle/WsHVnomb6rbVPnd18
- Payments to be made by Cheque or Bank Transfer (RTGS / NEFT)
- Cheque in favor of – Travflix Tours Private Limited
Bank Account Details:
- Bank Name: HDFC Bank
- A/C No.: 50200106139380
- IFSC: HDFC0000424
- Branch Name: Matunga Eastv
- PAN Number – AALCT6677N
- Udyam Registration Number – Udyam -MH – 19-0366130
- GST Number - 27AALCT6677N1ZA
Enquire Now
Why Exhibitors Choose Travflix?
- Seamless Trade Fair Participation
- Tailored Exhibitor Packages
- Prime Networking Opportunities
- End-to-End Travel & Logistics
- Marketing & Visibility Support
- On-Site Assistance
- Proven Expertise in MICE & Trade Fairs
